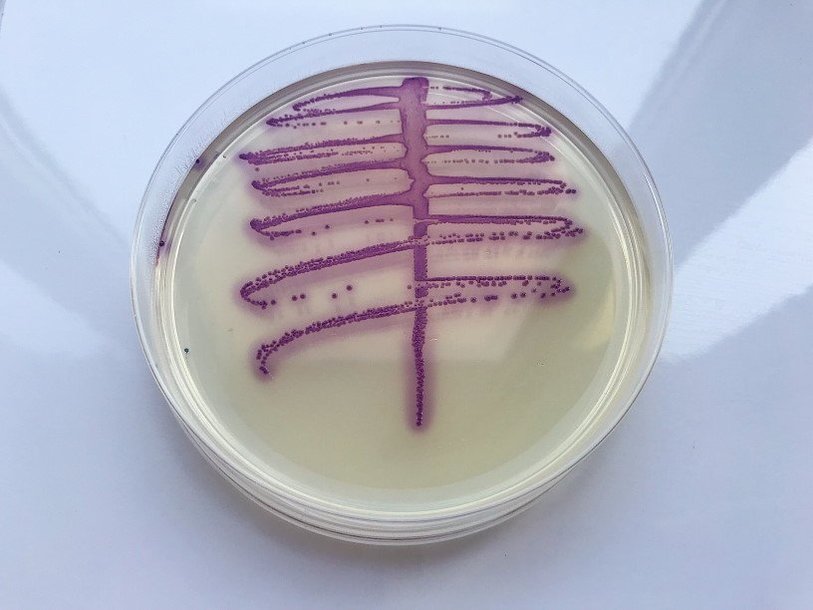

Екатерина Беленко: Промикробы: Волшебная палочка
E. coli в чашке Петри Фото: Екатерина Беленко
E. coli в чашке Петри Фото: Екатерина Беленко Escherichia coli — один из самых изученных микроорганизмов. Да что там микро-, кишечная палочка — один из самых изученных организмов вообще! Ее легко выращивать в лабораторных условиях, поэтому кишечная палочка играет важную роль в генетических исследованиях. E. coli является одним из самых важных объектов биотехнологии и микробиологии. Кишечная палочка была описана немецким педиатром и бактериологом Теодором Эшерихом в 1885 году, в честь него и стала эшерихией, как и другие ее родственники, относящиеся к роду Escherichia, но не являющиеся coli.
Кишечная палочка является грамотрицательным микроорганизмом, а по форме, как вы наверное догадались, палочкой. Она широко распространена в нижней части кишечника теплокровных животных. Большинство штаммов E. coli безвредны, однако есть серотипы, которые могут вызывать тяжелые пищевые отравления у людей и животных. Безвредные штаммы являются частью нормальной флоры кишечника человека и животных. Ученые пока не пришли к единому мнению, когда именно E. coli поселяется в наших кишках: по одним оценкам — за первые 40 часов жизни, а по другим — еще в утробе матери. И кишечная палочка остается с нами на всю жизнь! Вот по-настоящему крепкие отношения, не то что с бывшими.
Кишечная палочка — очень хороший арендатор, она платит за уютное жилье тем, что предотвращает развитие патогенных микроорганизмов в кишечнике хозяина, а также синтезирует витамин К. Он необходим для синтеза белков, обеспечивающих нормальный уровень коагуляции крови, играет значительную роль в обмене веществ в костях и в соединительной ткани, а также в здоровой работе почек. Во всех этих случаях витамин участвует в усвоении кальция и в обеспечении взаимодействия кальция и витамина D.
Но такой добренькой кишечная палочка остается, пока она на своей территории. В других частях организма она перестает помогать и начинает вредить. E. coli в моче может означать воспалительный процесс в почках, мочевом пузыре или мочеточнике. Во влагалище — кольпит. В предстательной железе — простатит. Попав в брюшную полость, может вызвать перитонит. Вот вам и добрый сосед-помощник... Лечат такие случаи антибиотиками, однако кишечная палочка может быстро приобретать лекарственную устойчивость.
Способность кишечной палочки некоторое время выживать в окружающей среде делает ее важным индикатором для исследования образцов на наличие фекальных загрязнений. Разные штаммы E. coli часто специфичны для определенных хозяев, что делает возможным определение источника фекального заражения в образцах. Допустим, если известно, какие штаммы E. coli представлены в образце воды, можно определить источник заражения — человек, другое млекопитающее или птица. На случай, если вам важно, кто воспользовался вашим прудиком в качестве туалета...
Смотрите также: Екатерина Беленко Промикробы: Ода кишечной микрофлоре Екатерина Беленко Промикробы: Грибы большие и маленькие Екатерина Беленко Промикробы: моча, окутанная мифами Екатерина Беленко Промикробы: Знакомьтесь, синегнойная палочка!